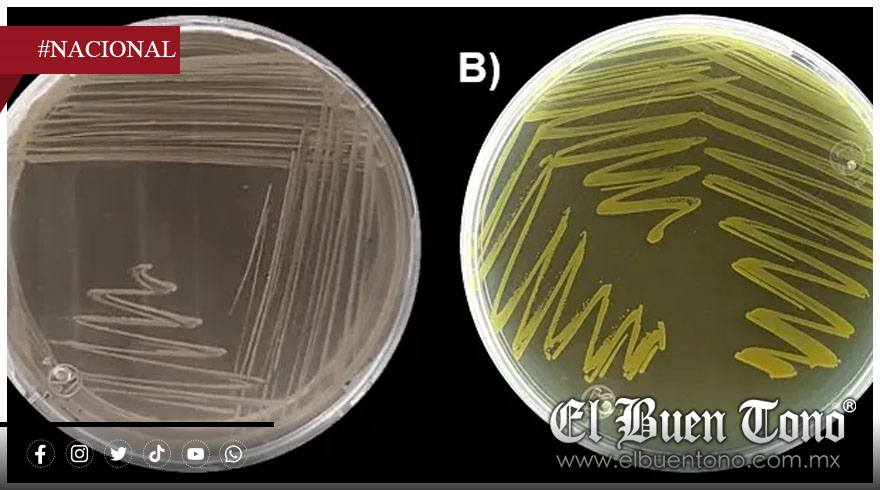

AGENCIA
Nacional.- Los investigadores de la Universidad Nacional Autónoma de México (UNAM) lograron identificar comunidades bacterianas en el Geoparque Mundial de la UNESCO Mixteca Alta, en Oaxaca, con capacidades excepcionales para mejorar la fertilidad del suelo y promover la restauración ecológica en zonas agrícolas tradicionales.
Estas comunidades de microorganismos benéficos, caracterizadas mediante técnicas avanzadas de secuenciación genética, destacan por su habilidad para suprimir patógenos, mejorar el ciclado de nutrientes como carbono y nitrógeno, y generar materia orgánica estable. Gracias a estos hallazgos, la región puede desarrollar biofertilizantes locales que reduzcan la dependencia de agroquímicos industriales, promoviendo prácticas agrícolas más sostenibles.
Este descubrimiento biotecnológico, resultado del estudio de sistemas agrícolas ancestrales, posiciona a la Mixteca como un ejemplo global de sostenibilidad. La integración de la ciencia genómica con los conocimientos tradicionales de las comunidades locales abre nuevas posibilidades para recuperar suelos degradados y mejorar la productividad agrícola, en línea con un modelo de desarrollo respetuoso con el medio ambiente.
Datos sobre el hallazgo de las bacterias
El hallazgo se realizó en suelos de sistemas agrícolas tradicionales conocidos como lama-bordos, terrazas y valles, manejados por comunidades indígenas durante más de 3,400 años. Los microorganismos identificados tienen la capacidad de potenciar la fertilidad del suelo, promover el ciclo de nutrientes y mejorar la estructura física del terreno, fortaleciendo la salud del ecosistema agrícola.
Mediante técnicas de secuenciación genómica, específicamente análisis del gen 16S rRNA, los científicos detectaron la presencia de grupos bacterianos dominantes como Proteobacteria, Actinobacteria, Acidobacteria y Chloroflexi, además de familias específicas como Solibacteraceae y Sphingomonadaceae.
Este descubrimiento no solo permite la elaboración de biofertilizantes y bioestimulantes adaptados a las condiciones locales, sino que también ofrece una herramienta para recuperar suelos degradados y aumentar la productividad agrícola bajo un enfoque sustentable y respetuoso con el medio ambiente.
Sinergia de conocimientos
El estudio resalta cómo el manejo tradicional ancestral ha creado ambientes ideales para estas comunidades bacterianas, demostrando que la ciencia moderna puede complementarse con los saberes tradicionales para generar soluciones sostenibles. La combinación de ambos conocimientos posiciona a la Mixteca como un referente en innovación ecológica y agricultura sustentable a nivel mundial.